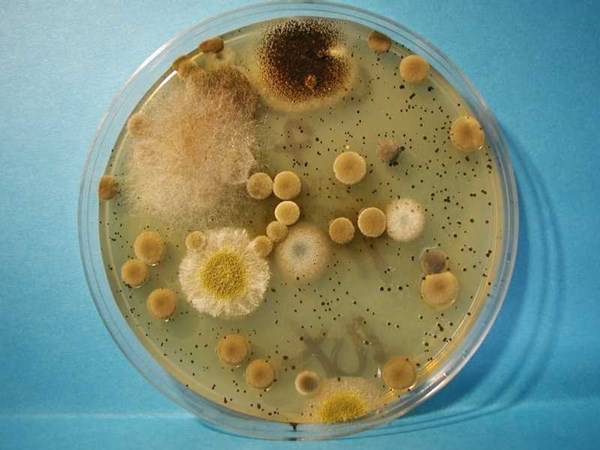
muffe in un vetrino

News

Grazie al reality “Hotel 6 stelle” il mondo del lavoro apre alle persone con la Sindrome di Down
Maria Sole Bosaia
Il successo del reality televisivo "Hotel 6 stelle" ha portato a un incremento dell'interesse delle aziende nei confronti delle persone con la Sindrome di Down. Speriamo sia solo un inizio!

Lix: la penna 3D che disegna per aria, senza bisogno di fogli – (Video)
Maria Sole Bosaia
Lix 3D è la penna che disegna direttamente in 3D. Attraverso un'avanzata tecnologia sarà possibile sbizzarrire la creatività.

Quali sono i motivi per cui le donne italiane non fanno figli?
Valentina Colmi
L'Istat ha stimanto che nel 2050 ci saranno 263 anziani ogni 100 persone giovani. Perchè succede in Italia?
Le muffe sono un pericolo per la salute spesso sottovalutato
Michele
Allergie, infezioni e patologie vengono veicolate dalle muffe: un pericolo da non sottovalutare soprattutto per chi ha bambini piccoli.

Beneficienza e bambini: quali i criteri con cui scegliere le associazioni da sostenere?
Francesca Nicoletti
Tutelare i buoni di cuore, privarsi di qualcosa per donarla a chi è più bisognoso di lui...tutto molto bello! Ma come si sa se gli aiuti dati arrivano davvero? Obama in America sta cercando di farlo, e da noi?

Volontari per il mondo Onlus (FOTO)
Maria Sole Bosaia
Come fare per sostenere Volontari per il Mondo, associazione che si occupa del sostegno alle popolazioni del Terzo mondo.

Economia killer: ad ogni taglio della spesa pubblica corrisponde un aumento dei suicidi
Maria Sole Bosaia
Una nuova ricerca sottolinea come i tagli economici possano avere influenza sulla scelta di suicidarsi della popolazione maschile.

Lui russa? I consigli di un esperto in medicina del sonno
Maria Sole Bosaia
Il russare e l'apnea del sonno non vanno presi alla leggera. Ecco alcuni consigli di un esperto in Medicina del Sonno

Sei sicuro che i “clochard” che incontri per strada non siano persone conosciute? (VIDEO)
Michele
Riconosceresti tua madre se chiedesse l'elemosina? Un video commovente ci mostra la risposta.

In forma per l’estate: 7 consigli indispensabili per tutte le donne
Maria Sole Bosaia
Alcuni consigli su come portare a termine una dieta in modo efficace.

Social network e adolescenti: madre pubblica video in cui picchia la figlia per aver pubblicato delle foto osè (VIDEO)
Francesca Nicoletti
Una mamma punisce severamente la figlia 12enne per aver pubblicato alcune foto osè su Facebook. Il web insorge. Ecco cosa è successo.

Padri, aiutereste le vostre figlie a cantare la colonna sonora del loro film preferito? (VIDEO)
Maria Sole Bosaia
Alcuni papà assecondano la passione delle figlie per il cartone animato Frozen, inscenando splendidi duetti canori sulle note di "Love Is An Open Door".

Non può piu’ essere padre, ma grazie alla chirurgia plastica corona il suo sogno! (FOTO & VIDEO)
Michele
Da bambino gli amputano il pene, ma grazie alla ricostruzione di un chirurgo diventa padre!

Salute e sanità: in quale regione è meglio vivere? Risponde il rapporto di Osservasalute.
Michele
Quali le migliori e le peggiori regioni italiane in fatto di salute e livelli di servizi sanitari garantiti? "Osservasalute" è il rapporto che indica tutte le performance della sanità in Italia.

Per salvare la vita della figlia 2 genitori realizzano l’impossibile! (video)
Michele
Due genitori raccolgono più di cinquecentomila dollari in due settimane per iniziare le cure necessarie a salvare la propria figlia.